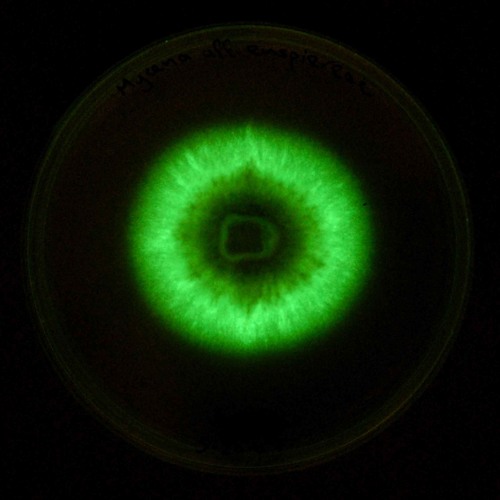

London Keys

👉🏻👉🏻👉🏻 ALLE INFORMATIONEN HIER! KLICKE HIER 👈🏻👈🏻👈🏻
London Keyes - IMDb
London Keyes - Wikipedia
London Keyes — Wikipédia
London Keyes (@LondonKeyes) • Twitter
London Keyes (@londonkeyes) • Instagram photos and videos
London Keyes - Biography - IMDb
Sex Mit Papa Deutsch
Hentai Erotik
Hausgemacht Porn
Ehefrau Fotze
Anal Orgasmen
London Keyes . Actress . Lovely, buxom, and shapely brunette stunner London Keys was born Cora Birdwell on August 18, 1989 in Seattle, Washington . She's of mixed Japanese and Caucasian descent . London first began performing in explicit hardcore movies in her late teens in 2008; she has appeared in X-rated features for such top companies as Vivid, . . .
London Keyes (* 18 . August 1989 als Cora Birdwell in Seattle, Washington, USA) ist eine US-amerikanische Pornodarstellerin und Erotikmodel .
London Keyes est née le 25 août 1989 à Seattle . Métisse d'origines caucasiennes et asiatiques, elle est née d'un père américain et d'une mère japonaise . Strip-teaseuse à la fin de son adolescence, c'est à l'âge de 19 ans, en 2008, qu'elle entame sa carrière d'actrice dans le milieu de l' industrie pornographique .
Die neuesten Tweets von @londonkeyes
549 .6k Followers, 785 Following, 116 Posts - See Instagram photos and videos from London Keyes (@londonkeyes)
Lovely, buxom, and shapely brunette stunner London Keys was born Cora Birdwell on August 18, 1989 in Seattle, Washington . She's of mixed Japanese and Caucasian descent . London first began performing in explicit hardcore movies in her late teens in 2008; she has appeared in X-rated features for such top companies as Vivid, Penthouse, Hustler, Evil Angel, Pure Play Media, New Sensations, and Elegant Angel . Keys has several tattoos as well as piercings in her tongue, navel, right nostril, left . . .
Frauen Selbstbefriedigung Video
Rita Will Endlich Auf Ihre Kosten Kommen - Pornhub Deutsch
Lustvolle Cheerleaderin Moka Mora Unternimmt Einen Ausflug - Pornhub Deutsch
Dominante Lady
Milf Besamung
Männer Abmelken
Italienisch Porno
Tatto - Pornos Deutsch
Shemale Xhamster
Zwei Ukrainerinnen Im Badezimmer - Pornhub Deutsch
Swinger Fotzen
Busen Fick
Reife Frau Liebt Es Wild Und Hart - Pornhub Deutsch
Spy Pussy
Porno Teen Amateur
Sexy Bitch Nackt
Amateur Gefickt
Anal - Pornos Deutsch
Porno Pferd Fickt Frau
Dirtyflix
Junges Paar Beim Ficken
Porn.Net
Mutti Mit Monstertitten Fickt Schwarzen Schwanz - Pornhub Deutsch
Teen Ganbang
Eine Blonde Cougar Mit Faketitten Ind Nylons Und Heels Beim Ao Sex - Pornhub Deutsch
Mutter Zum Ficken Gezwungen
Kostenlose Sexviedios
Junge Pornodarsteller
Arschfingern
Black Sex
Bilder Von Jungen Nackten Frauen
Geiler Hintern - Pornos Deutsch
Ebony Baby Aus Kanada - Pornhub Deutsch
Fotze Am Strand
Porn Lesben
Hardcore Teenager Und Ihre Auflaufende Fotzen - Pornhub Deutsch
Luna Love 96 Porn
Schlampe Liebt Gummi-Sexspielzeuge Teil 5 - Pornhub Deutsch
Deutsche Großmutter Beim Hardcorsex - Omi Macht Die Beine Breit - Pornhub Deutsch
Erotikfilme Kostenlos Hd
Alles Schlucken - Pornos Deutsch
Junge Muschies
Blowjob Cum
Pornovideos - Pornos Deutsch
Die Anmacherinnen, Glühende Fötzchen
Junge Kerle Ficken
Xxx Blond
Ficken Im Wohnzimmer
Kehlenfick Porno
Der Anal Lehrer - Pornhub Deutsch
German Cumshot Compilation
Reiche Schwanze Die Armen Verdorbenen Hausfrauen Brauchen Geld Und Sex - Pornhub Deutsch
Ehefrau Fotze
Mutti Und Teen Nehmen Sich Einen Bbc - Pornhub Deutsch
Xhmasters
Janice Griffith Dp
Babe Im Dirndel Mit Sexy Rundem Arsch Und Ordentlich Holz Vor Der Hutten - Pornhub Deutsch
Gratis Porno Lecken
Monster Pimmel
Porno Deutsch Lesben
Gratis Amatör Porno
Britin Steht Auf Lange Schwarze Schwanze - Pornhub Deutsch
Adria Rae
Schone Mum In Strumpfe Will Analfick - Pornhub Deutsch
Teen.Porno
Geile Chick Blast Und Reitet - Pornhub Deutsch
Sexurlaub Kenia
Jungfrau Beim Wichsen Erwischt Und Gefickt - Deutsche Pornos Kostenlos
Süsse Muschi
Sexy Studentinnen
Brünette Frauen Nackt
Pornostar Mieten
Die Neue Austausch Studentin Kann Gut Blasen
Schmutzige Reife Milf Eine Erfahrene Reife Dame Will Das Mit Ihr Wichst - Pornhub Deutsch
Www Schwule Pornos De
Amateur Deepthroat
Nackte Lesbe
Futurama Porno
Anime Transen Porno
Sperma Tube
Pissen Und Scheissen - Pornos Deutsch
Nackte Pornostars
Fette Reife Frauen
Fotze Mit Schwanz
Hubsche Teenagerin Spielt Mit Ihrer Pussy Vor Der Webcam - Livesex - Pornhub Deutsch
Transsexuelle Ficken
Kostenlos Fiken
Reife Frauen Lieben Bbc - Pornhub Deutsch
Sex Videos Deutschsprachig
Analhuren Vor Der Kamera - Amateur Arschfick - Pornhub Deutsch
Großer Geiler Arsch
Faltige Oma Ersetzt Sich Den Schwanz - Pornhub Deutsch
Anjelica Porno
In Alle Löcher Gefickt
Lack Und Leder Sex
Arschgefickt Vom Haarigen Schwarzen Mann - Eine Zierliches Langbeiniges Titten Teen Beim Interracial Geschlechtsverkehr - Pornhub Deutsch
Sexy Fotze-Amateurblondine Mit Prallen Brusten - Pornhub Deutsch
Grosser Schwanz Porn
Mutters Titten
Huren Einreiten
London Keys























![]()

![]()




![]()
![]()

























![]()




